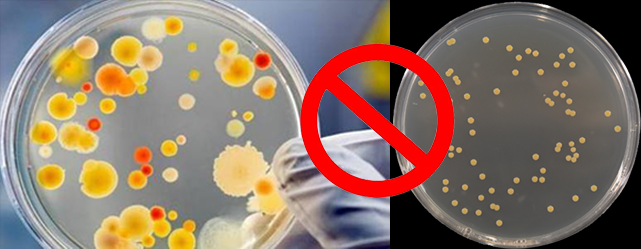

清洁“万能泡”!泡沫清洗剂到底有多厉害
在食品生产加工的全链条中,“清洁”是守护安全的核心环节。而泡沫清洗剂凭借其独特的配方和超强适配性,被行业内称为清洁“万能泡”——它既能攻克顽固污垢,又能适配多场景需求,成为多食品行业保障卫生安全、提升生产效率的“标配利器”。

一、什么是泡沫清洗剂?
以碱性泡沫清洗剂为例,它是一类以碱性成分(如氢氧化钠、碳酸钠等食品级合规成分)为核心,搭配表面活性剂制成的清洁产品,其核心优势在于“泡沫形态+碱性配方”的双重赋能:
泡沫特性:能产生绵密、附着性强的泡沫,些泡沫就像“立体清洁网”,喷洒后可牢牢吸附在设备表面,不会快速流失,延长与污垢的接触时间;同时又能深入设备缝隙、管道内壁、模具纹路等常规清洁难以触及的角落,实现“无死角包裹”。
碱性原理:碱性成分可与食品生产中常见的油脂、蛋白质、淀粉等有机污垢发生皂化、分解反应,将顽固污渍转化为易溶于水的物质,后续冲洗即可轻松去除,避免化学残留。
值得注意的是,食品行业专用的碱性泡沫清洗剂需通过严格的食品级认证,确保清洁后无有害残留,可直接用于与食品接触的设备表面。

二、“万能泡”的应用版图:食品相关行业全覆盖
1.饮料&酒业:搞定粘性残留,守护纯净口感
无论是果汁的果肉纤维、茶饮的茶垢、碳酸饮料的糖分残留,还是白酒的酒槽附着物、啤酒的酵母沉淀,碱性泡沫清洗剂都能轻松应对。
应用场景:灌装机喷嘴、储液罐内壁、输送管道、发酵罐、过滤设备;
清洁亮点:泡沫深入管道缝隙分解粘性污渍,避免微生物滋生影响饮品品质,且易冲洗无残留,不破坏酒体或饮料的原有风味。
2.乳制品&肉制品:瓦解顽固污垢,杜绝污染风险
乳制品生产中的奶垢、蛋白质结块(如巴氏杀菌机、奶罐车),肉制品加工中的油脂、肉渍残留(如绞肉机、腌制槽、切割台),都是清洁难点。
应用场景:杀菌机、发酵罐、奶酪模具、绞肉机孔洞、灌肠机管道;
清洁亮点:碱性配方强力分解蛋白与油脂,泡沫包裹设备死角,清洁同时兼具抑菌效果,从源头避免产品变质。
3.烘焙&糖果行业:清除粘性残留,保障造型与风味
烘焙设备上的面粉、蛋液、油脂混合物(烤箱、和面机、蛋糕模具),糖果生产中的糖浆、可可脂残留(熬糖锅、糖果模具),粘性强且难清理。
应用场景:烘焙模具、裱花嘴、熬糖锅、浇注设备;
清洁亮点:泡沫深入模具纹路,软化粘性污渍,清洁后设备无残留,不影响点心、糖果的造型完整度和口感。
4.水产&预制菜行业:去除腥味污渍,提升清洁效率
水产加工中的鱼腥味黏液、蛋白质残留(剖鱼机、速冻设备),预制菜生产中混合食材的油污、酱料残留(中央厨房炊具、分装线),清洁频率高且需求复杂。
应用场景:水产剖切设备、中央厨房炒炉、分装容器、冷却架;
清洁亮点:快速分解腥味污垢,泡沫清洁无需反复擦拭,适配高频清洁需求,提升生产效率。
5.粮油&果冻行业:应对粉尘油脂,避免二次污染
粮油加工中的油脂残留(榨油机)、面粉粉尘结块(输送管道),果冻生产中的胶质、水果颗粒残留(熬制锅、果冻模具),易造成二次污染。
应用场景:榨油设备、面粉输送管道、果冻模具、储料罐;
清洁亮点:泡沫吸附粉尘与油脂,分解胶质残留,避免原料被设备污染,保障产品纯度。

三、“万能泡”的核心优势:不止于清洁
除了适配多行业场景,碱性泡沫清洗剂还具备以下核心价值:
安全合规:食品级配方,通过行业安全认证,清洁后无化学残留,不影响食品品质;
高效省耗:泡沫附着性强,无需大量清水冲洗,既节省水资源,又缩短清洁时间;
保护设备:温和配方不腐蚀金属、塑料等设备材质,延长设备使用寿命。
杀菌消毒(含氯泡沫):清洁消毒一体化,含氯成分可广谱杀灭大肠杆菌、金黄色葡萄球菌、沙门氏菌等食品行业常见致病菌,尤其适配肉制品、水产等微生物污染高风险场景;无需额外搭配消毒剂,减少二次工序;同时氯成分与碱性配方协同作用,去污的同时抑制细菌繁殖,双重保障食品安全。
作为食品级清洁方案的提供者,我们的泡沫清洗剂系列通过严格国标认证,适配饮料、乳制品、烘焙、水产、酒业、糖果等多行业需求,实现“清洁+消毒”双效,助力食品企业高效生产、保障舌尖安全。
选择我们,让每一个食品生产环节都“净”在掌握!
👉关注源头厂家,获取更多洗消整体解决方案!
推荐文章
-
近日,迅清生物举办生产安全专项培训会议,公司生产部、供应保障部、技术质量保证部等多个部门员工参会。此次培训以“生产安全培训”为主题,旨在全面提升全员生产安全防护意识和能力,构筑全链条安全屏障。 培训伊始,安全管理负责人李总结合化学品企业生产特性,系统解读《危险化学品安全管理条例》等核心法规,明确“全要素、全过程”的安全管理要求。针对迅清生物研发生产中的关键风险点,培训重点围三大核心模块展开: 重点风险识别与管控:通过风险矩阵分析法,详解危险化学品储存与运输防泄漏、易燃易爆物品保管与使用防火灾等关键环节潜在风险,建立“红黄蓝”三级预警机制,明确各风险点具体管控责任人; 标准操作规程:结合危险化学品和易燃易爆物品特性,梳理从采购、入库、使用到废弃的全流程操作规范,强调个人防护装备规范穿戴、专用存储设备日常检查等要点,确保每个操作环节责任到人; 应急处置流程:结合国内危险化学品泄漏、易燃易爆物品火灾典型案例,拆解事故应急响应流程,明确“事故报告—现场...
-
2025年的乳品行业正在经历“品质革命+绿色转型”双重洗礼:灭菌乳新规禁用复原乳倒逼原料升级,超70%的消费者紧盯“零添加”,植物基奶年增15%分走市场,欧盟CBAM政策卡紧出口碳足迹…… 而藏在这些变化背后的生产细节里,清洗剂早已不是“配角”,而是决定乳品企业能否合规生产、守住品质、赢得市场的关键一环。...
-
10月14日,第45届中国洗涤用品工业协会年会上,安洁凭借过硬技术实力,斩获2025中国日化展“安全除菌创新奖”!
